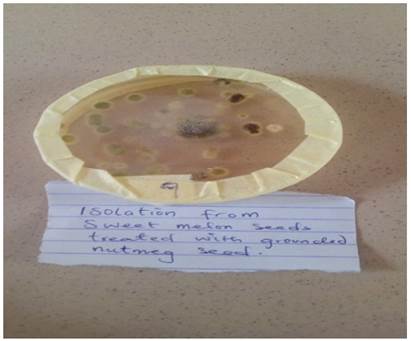

Biocidal-Efficacy Of GONGRONEMA latifolium, Myristica fragans And Alpron- Plus On Seed Health, Germination Percentage, Seedling Vigour Of Sweet Melon (Cucumis melo L.) Seeds And Associated Fungi organisms
Iwuagwu Christian Chukwunenye 1![]()
,
Mbanekwu Precious Mmesoma 1
, Aguwa
Uwaoma Otuodichima 1![]()
, Iheaturu Donald. Ezechukwu 1![]()
,
Apolowo Oluropo Ayotunde 1![]()
,
Ejiofor Mary-Geraldine Ebele 1![]()
, Iwu, Doris Chioma 2![]()
1 Department of Crop Science and
Horticulture, Nnamdi Azikiwe University, Awka,
Anambra State, Nigeria
2 Department of vocational education,
Nnamdi Azikiwe University, Awka, Anambra State,
Nigeria
|
|
ABSTRACT |
||
|
Laboratory experiment was conducted to test the effects
of bio-medicinal plants (Gongronema latifolium (Utazi) leaves and
Myristica fragans (Nutmeg) seeds) and synthetic
fungicide (Alpron- Plus) on seed health,
germination percentage and seedling vigour of sweet
melon seeds. The experiment was conducted at the Crop Science and
Horticulture Laboratory, Nnamdi Azikiwe University Awka,
Anambra State. Bio-medicinal plants were used as crude powdery seed dressers
as well as synthetic fungicide. The experiment was laid out in a simple
completely randomized design (CRD) with ten replications which consisted of
blotter paper germination/ seed health tests of sweet melon seeds and
seedling vigour and seedling vigour
index tests using soil medium. Ten petri dishes and ten polybags were used
respectively for each of the plant extracts and synthetic fungicides
simultaneously for both blotter paper and soil medium tests. Twenty seeds
which were independently dressed in various plant extracts and synthetic
fungicide were plated into one 9cm Petri dish containing three layers of
blotter paper in circular form. For
soil medium method, ten polybags with few small perforations underneath
filled with sterilized topsoil were used for each fungicide. The Petri dishes
containing the plated seeds were incubated on the Laboratory benches for
eight days while seedlings in polybags were kept in the screenhouse and
observations were taken and recorded daily for germination count, fungal
growth then germination index and seedling vigour
index which were derived later with appropriate formulae and their values
being expressed in percentages. The results of this investigation revealed
that bio-medicinal plant crude extracts had significant effect on germination
percentage and germination index of Sweet- melon seeds. Gongronema
latifolium crude extract had the highest
germination index. The synthetic fungicide was effective in protecting the
seeds of sweet melon though had low germination percentage. Nutmeg was not
effective when used in crude powdery form as dressers as it had the lowest germination
percentage and the highest infestation percentage. It could therefore be
recommended that the plant extracts tested in this experiment should not be
used as powdery seed dressers but as essential oil using appropriate
extracting solvents in order for the bioactive
ingredients to act effectively in preventing micro-organisms that hinder
germination of sweet melon seeds. |
|||
|
Received 16 October 2022 Accepted 17 November 2022 Published 01 December 2022 Corresponding Author Iwuagwu Christian Chukwunenye, chrisiwuag@yahoo.com DOI10.29121/granthaalayah.v10.i11.2022.4680 Funding: This research
received no specific grant from any funding agency in the public, commercial,
or not-for-profit sectors. Copyright: © 2022 The
Author(s). This work is licensed under a Creative Commons
Attribution 4.0 International License. With the
license CC-BY, authors retain the copyright, allowing anyone to download,
reuse, re-print, modify, distribute, and/or copy their contribution. The work
must be properly attributed to its author.
|
|||
|
Keywords: Bio-Medicinal Plants, Alpron-
Plus, Sweet Melon, Seedhealth, Germination
Percentage, Seedling Vigour |
|||
1. INTRODUCTION
Sweet melon (Cucumis melo L) also known as cantaloupe is a vining plant in the family of Cucurbitaceae, grown for its large, sweet fruit Cobbley et.al. (1978). Sweet melon vines are trailing and are slightly hairy with simple oval leaves arranged alternately on the stem Munger and Robinson (1991). The plant produces small yellow flowers which are 1.2–3.0 cm (0.5–1.2 in) in diameter and large oval to round fruit with green to orange flesh. Sweet melon is an annual plant, and a vine can grow up to 3 m (9.8 ft) in length. Sweet melon may be referred to as muskmelon or melon and likely originate from East and Northeast Africa (Cantaloupe). Sweet melon can be served as dessert Munger and Robinson (1991). It contains 90% water, 8% carbohydrates, 0.8% protein and 0.2% fat, providing 140 KJ (34 kcal) and 2020 μg of the provitamin A orange carotenoid, beta-carotene per 100 grams. Fresh sweet melon is a rich source of vitamin C and vitamin A, with other nutrients in negligible amount Olayinka and Etejere (2018). Sweet Melon is medicinal. It has antioxidant properties that can help prevent cell damage that can lead to cancer and other health conditions Petkova and Antova (2015). During metabolism, the body produces unstable molecules called free radicals, which can collect in the body and damage cells. This damage is known as oxidative stress. Antioxidants help remove free radicals from the body and prevent oxidative stress. Canteloupe contains a range of antioxidants, including: selenium, beta carotene, vitamin C, lutein, zeaxanthin, and choline. Sweet melon aids in digestion, it has a high-water content and provides fiber Rubatzky and Yamaguchi-Mas (1997). In 2016, global production of melons, including cantaloupes, totaled 31.2 million tons, with China accounting for 51% of the world total (15.9 million tons). Other significant countries growing cantaloupe were Turkey, Iran, Egypt, and India producing 1 to 1.9 million tons, respectively FAOSTAT (2017). Seed is the basic unit of production for the world’s food crop Rajput et al. (2005). In recent years seed has become an international commodity used to exchange germplasm around the world. Seed is however, also an efficient means of introducing plant pathogens into a new area as well as providing a means of their survival from one cropping season to another Walcott (2003). There are seed borne fungi that are found on the surface and inside of the seeds. This is one of the important constraints resulting in the deterioration of seed quality. These fungi cause reduction in the nutritive value of seeds and reduce seed viability Van Du et al. (2001). Seed treatment is the safest and cheap method to prevent deterioration of seed quality and crop loss in fields Niaz and Dawar (2009). Studies have shown that seed treatment or dressing with fungicides and other agents such as plant extract have shown reduced incidence of seed borne fungi and promotion of germination and seedling growth. The seedborne pathogens may result in loss of germination, discoloration and shriveling, development of plant diseases, distribution of pathogen to new areas, introduction of new strains or physiologic races of the pathogen along with new germplasm from other countries and toxin production in infected seeds Niaz and Dawar (2009). For adequate management of challenges associated with seedborne disease the pathogens need to be isolated and identified. Seed borne fungi pathogen could be identified using blotter paper method, agar plate method, use of microscope or use of illustrated diagrams of fungi Barnett and Hunter (1999) In seed health testing for seed-borne fungal pathogens the blotter test is no doubt one of the most important methods available Limonard (1966). Blotter tests are similar to germination tests in that seeds are placed on moistened layers of blotter paper and incubated under conditions that promote fungal growth. Agar plate is also a common method used for identification of seed borne fungi Rao et al. (2006). Incubation methods allow the detection of viable fungal material even at the preliminary phase of development of the fungus. This is done generally by placing seeds onto sterile agar media (potato dextrose or malt agars- (PDA) are most commonly used) to encourage the growth of seed borne fungi. Scanning electron microscopy (SEM) as a potential alternative to study seed-borne fungi in seeds, by two different conditions of blotter test and water restriction treatment; this one can do with the aid of a microscope Nascimento Gislene et al. (2000).
In order to circumvent the adulteration and high toxic effect of synthetic fungicides, intensive studies on extracts and biologically active compounds isolated from plant species used for natural therapies or herbal medicine has been on going. Rios and Recio (2005). Medicinal plants represent a rich source of antimicrobial agents. There are varieties and wide range of medicinal plants that inhibit fungi pathogen activities hence promote seed germination and increase seedling vigor. This is because of their anti-microbial, anti-cancerous, anti-fungal properties Srivastava et al. (1996). Medicinal plants like nutmeg (Myrristic frangran) has shown strong antimicrobial activity against numerous bacteria and fungi due to presence of various compounds like carvacrol, γ-cymene, α-pinene, β-pinene, and β-caryophyllene in its essential oil Shafiei et al. (2012). The leaf extract of Utazi (Gongronema latifolium) also exhibits antibacterial activity, an anti-ulcer, and analgesic, with antipyretic properties. Phytochemical analysis of the ethanolic extract of G. latifolium shows that the root contains polyphenols in abundance. Alkaloids, glycosides, flavonoids, terpenes, tannins, saponins and reducing sugars are also present in moderate amounts. These is also applicable to other medicinal plants like cinnamon, cloves, ginger, onion, garlic etc. Most subsistent and commercial farmers have at one time or the other experienced seed germination failure, which many a times have thrown them into dilemma what the cause of the failure could have been. It is obvious that at such huge financial loss is incurred resulting from increased input cost for seeds for replanting, labour cost for the replanting and time wastage. To avoid this kind of setback, it becomes pertinent that seed viability and health tests should as a necessity be carried out especially for fragile seeds with very short viability shelf life, at such, the motive for this study.
2. MATERIALS
AND METHODS
2.1. Experimental Site
The study was carried out in the Laboratory of the Department of Crop science and Horticulture Nnamdi Azikiwe University, Awka.
2.2. Source of Materials
The Sweet melon seeds were sourced from a certified Sweet melon farmer in Ibadan. The synthetic fungicide used, Alpron plus 60 SD with active ingredient 205 cypermethrine which was used as seed dressant was purchased from Onitsha drug market. The medicinal plant materials used Gongronema latifolium (Utazi) leaves and Myristica fragans (Nutmeg) seeds were purchased from Eke-Awka and Nkpor Markets respectively.
2.3. Seed health/Viability Tests using Blotter Paper Method
Ten petri dishes were used for each of the plant extracts and synthetic fungicides simultaneously. The control consisted of one Petri dish with untreated seeds of sweet melon. Sweet melon seeds which were dressed with the crude powdery plant extracts and synthetic fungicide were plated on Petri dishes containing three layers of blotter paper moistened with distilled sterile water. A total of thirty -one plates were used for the sweet melon seeds treated with the various plant extracts and synthetic fungicide.
2.4. Seed
Germination Vigour Test using Soil method
Thirty- one polybags each containing one kilogram of sterilized topsoil were used for seedling vigour and seedling vigour index tests. Ten polybags with small underneath perforations were used for each of the treatments.
2.5. Experimental Set-up using Blotter Paper Method
Two hundred healthy seeds of sweet melon were used for
each of the plant extracts and synthetic fungicide. Twenty seeds which were
dressed with a particular plant extracts or synthetic
fungicide were plated one after the other using 9cm Petri dish containing three
layers of blotter paper in circular form.
Each petri dish having three layers of blotter papers moistened with distilled
sterile water, and twenty sweet melon seeds plated in a ring form with ten
seeds in the outer ring, nine in the second ring, and one in the center. Ten
Petri dishes were used for each of the plant extract or Alpron- Plus. Each
Petri dish was held together with a rubber band to prevent the lid being pulled
out by the germinating seeds. The Petri dishes containing the plated seeds were
incubated on the Laboratory benches for eight days and observations were taken
and recorded daily for germination count and fungal growth
which were later expressed in percentages.
2.6. Experimental procedure for seedling
vigour test using soil method
Crude powdery extracts of Utazi leaves, Nutmeg seeds and Alpron-plus were also used for this procedure. The topsoil was sterilized by boiling for three hours at a temperature of 120ºC and later allowed to cool. Then one kilogram of sterilized soil was measured into each black polybag perforated underneath. The sweet melon seeds were dressed separately with the plant extracts or synthetic fungicides and also planted separately in the polybags containing the sterilized soil and watered lightly with sterilized water. Twenty sweet melon seeds were planted per bag. Ten polybags were used for each fungicide and a total of thirty-one polybags were used for the three fungicides, where one polybag served as the control. The melon seeds were planted at equal distance of 25x25cm in each polybag. The plumule length of the germinating melon seeds were measured by the use of a pair of dividers and transparent meter rule. These were later used for the calculation of the seedling vigour index.
2.7. EXPERIMENTAL
DESIGN
The experiment consisted of seeds of one variety of sweet melon treated with two plant extracts in powdery forms, and one synthetic fungicide separately as dust and laid out in a Completely Randomized Design (CRD) with ten replications. Plate 1, Plate 2, Plate 3.
Plate 1
|
Plate 1 Sweet Melon Fruit |
Plate 2
|
Plate 2 Sweet Melon Seeds |
Plate 3
|
Plate 3 Plated Seeds of Sweet Melon Treated with Different Bio-Medicinal Plants Extract as Dressers |
2.8. Data Collected
Germination percentage per plate, percentage infection per plant and later germination percentage and seedling vigour index were derived using the appropriate formulae.
2.9. Preparation of PDA for isolation of
fungi organisms associated with the germinating sweet melon seeds
Ten grams of potato dextrose agar (PDA) powder was weighed
with electronic scale and was carefully poured into a 250ml conical flask and
250ml of distilled water was then added and was stirred properly. The conical flask was corked with cotton wool
wrapped in aluminum foil. This was then autoclaved at a temperature of 120ºC
and pressure at 15psi for 20-25 minutes. After the preparation, the conical
flask containing the PDA was brought out of the autoclave and allowed to cool.
Ten milliliters of the prepared PDA were dispensed into each 9cm petri dish
with two drops of lactic acid to knock off bacteria growth. Four petri dishes
were used for the isolation of fungal organisms from each treatment.
2.10. Isolation of fungal pathogen
Firstly, the working table was surface sterilized with methylated spirit so as to prevent contamination. A sterile inoculation needle was used to place some portion of fungi from infected seeds of sweet melon into sterile petri dishes containing the PDA close to a burning flame of the spirit lamp. The Petri dishes were masked to prevent contamination, properly labelled, and later incubated on the Laboratory benches at a temperature of 27±1ºC for four days. Pure cultures were obtained after three consecutive sub-culturing and the pure cultures were properly kept for subsequent use.
2.11. Identification of isolated pathogen
The resulting pure culture were used for characterization and subsequent identification of the fungi isolates with the aid of a compound microscope (Olympus L 50 Model) with magnification of x100. The temporary slides were prepared by placing one drop of water on the slide and a small portion of the pure culture was collected with the aid of a sterile needle from the interface of the continuous growth and placed on the slide which was teased and later covered with the slide cover and viewed under the Microscope. The fungi were identified using illustrated pictures of fungi by Barnett and Hunter (1999), based on the morphological characteristics of the mycelium and the fruiting bodies. Micrograph of the identified fungi organisms were also taken.
1) Germination percentage: Percentage (%) seed germination per treatment at seven days of plating was calculated. The formula below was used ISTA (2001).
Germination % = Number
seeds germinated x 1_
Total number of seeds plated 100
2) Germination Index (GI): Germination Index (GI) = (10 x n1) + (9 x n2) + … + (1 x n10) where n1, n2 … n10 = No. of germinated seeds on the first, second and subsequent days until the 10thday; 10, 9 … and 1 are weights given to the number of germinated seeds on the first, second and subsequent days, respectively ISTA (2001).
3) Seedling vigor index (SVI): This was calculated by multiplying seedling plumule length of each germinated seed with standard germination percentage of the seeds in each polybag. That is, Seedling vigour index = seedling plumule length x germination percentage.
4) Data Analysis
All data
collected were later converted into percentages and presented in graphical
forms and chart.
3. Results
3.1. Effects of plant extracts and synthetic fungicide on germination percentage of sweet melon seeds
The result in Figure 1 below shows that germination occurred highest (75%) on the fourth day followed by third day with germination score of 25% while the least (10%) was obtained on the fifth and seventh day. From the chat it was observed that there was a zero germination on the first, second, sixth and eighth day. This shows that germination occurred most on fourth day. Also, it could be inferred that germination of sweet melon seed take up to seven days to be completed.
Figure 1

|
Figure 1 Effect of Nutmeg Extract on Germination
Percentage of Sweet Melon Seeds Using Blotter Paper Method |
Results of effects of powdery extracts of Gonglomera latifolia (Utazi) on germination of Sweet melon seeds in Figure 2 below shows that germination occurred most (70%) on the fourth day as was experienced in the seeds dressed with Nutmeg powdery extract, followed by (10%) obtained on the third day while the least (5%) occurred on the seventh day. It was also observed that there was no germination on the first, second, fifth, sixth and the eighth day. Also, it could be seen that it takes up to seven days for germination of sweet melon seeds to be completed.
Figure 2

|
Figure 2 Effect of Utazi Plant Extract on Germination Percentage of Sweet Melon Seeds Using Blotter Paper Method |
The results in Figure 3 below shows that there were fewer germinations of Sweet melon seeds dressed with synthetic fungicide using blotter paper method, though germination occurred most (4.5%) on the third day followed by (3%) obtained on the fourth day while the least (0.5%) occurred on the second day. It was observed there was no germination on the first, sixth, seventh and eighth day. The results in Fig 1.3 also shows that after the fifth day there was no germination of Sweetmelon seeds dressed with Apron Plus. Generally, it could be observed that synthetic fungicide (Apron Plus) did not favour the germination of Sweet melon seeds. Greater percentage of the seeds failed to germinate. The reason could that the synthetic fungicide had a phytotoxic effect on the seeds, since same seeds had higher germination percentage in the other treatments.
Figure 3

|
Figure 3 Effect of Synthetic Fungicide on Germination Percentage of Sweet Melon Seeds Using Blotter Paper Method |
3.2. Effects of plant extracts and synthetic fungicides on percentage infection n sweet melon seeds
Result in Figure 4 shows that highest infection (75%) occurred on seeds treated with Utazi, followed by that treated with Nutmeg (40%). It was also observed that there was a minimum infection (4%) on seeds treated with synthetic fungicide. This could have been as a result of the fungitoxic effect of the active ingredient in the synthetic fungicide used in this experiment. It could also be observed that the two bio- medicinal plants used in this investigation were not very effective in preventing microbial growth on the germinating Sweet melon seeds. This could have been as a result of the method of application of the plant extract, in a dust form instead of liquid extract that could have been applied as emulsion or in drenching/dipping form.
Figure 4

|
Figure 4 Effects of Plant Extracts and Synthetic Fungicide on Infection Percentage on Sweet Melon Seeds |
3.3. Effects of plant extracts and synthetic fungicides on germination index of sweet melon seeds
Result in Figure 5 below shows that plant extract from Utazi had the highest germination index of 42% followed by synthetic which had 33% while the least (25%) was obtained in Nutmeg plant extract.
Figure 5

|
Figure 5 Germination Index of Utazi, Nutmeg and Synthetic |
3.4. Effects of nutmeg extracts on percentage emergence of sweet melon seeds using polybag method
Results of effects of Nutmeg plant extract on percent emergence of Sweet melon seeds using soil methods in polythene bags in Figure 6 below shows that there was no emergence on the first, second, third and fourth day but on the fifth day with a percentage emergence of 1.5% which was similar to that obtained on the sixth and eighth day respectively followed by 1% on the ninth day while the least (0.5%) occurred on the seventh day. From the graph also it could be observed that it took longer time for the emergence of sweet melon seeds using soil method in polybags though germination of seeds must have taken place in the soil. Also, it took longer time for seed germination and emergence to be completed in the polybag method.
Figure 6

|
Figure 6 Effect of Nutmeg Extract on Emergence Percentage of Sweet Melon Seeds Planted in Polybags |
Figure 7

|
Figure 7 Effects of Utazi on Emergence Percentage of Sweet Melon Seeds Planted in Soil in The Polybags |
Results on effects of plant extract of Utazi in Figure 7 above shows that there were no emergence on the first, second, and the third day but emergence started on the fourth day. This trend was earlier observed in the effect plant extract of Nutmeg. It also shows that the highest (1.5%) emergence percentage occurred on the sixth day followed by (1%) which was obtained on the fourth, seventh and ninth day while the least (0.5%) was on the fifth day. From the graph it could also be observed that emergence of sweet melon seeds took up to nine days to be completed,
Figure 8

|
Figure 8 Effects of Synthetic Fungicide on Emergence Percentage on Sweet Melon Seeds Planted In Polybags |
From the result of the effects of synthetic fungicide (Apron Plus) in Figure 8 above, it was observed that there was zero emergence. This could have been as a result of phytotoxicity of the synthetic chemical used in dressing the sweet melon seeds in this experiment.
3.5. Effects of nutmeg extracts on seedling vigour index of sweet melon seeds planted in polybags
From the result in Figure 9, sixth day had the highest seedling vigour (4), followed by that on the fifth day (3.5) while the least (1) was obtained on the ninth day. The first, second, third and fourth day had zero emergence.
Figure 9

|
Figure 9 Effects of Nutmeg Extract on Seedling Vigour Index of Sweet Melon Seeds Planted In Polybags |
Figure 10

|
Figure 10 Effect of Utazi Extract on Seedling Vigour Index of Sweet Melon Seeds Planted in Polybags |
Results of effects of Utazi extract in Figure 10 above, shows that the highest seedling vigour (4) was obtained on the seventh day followed by (3.5) which occurred on the sixth day while the least (0.5) was on the fifth day. First, second, third and eighth day had zero emergence.
Figure 11

|
Figure 11 Effect of Synthetic Fungicide on Seedling Vigour Index on Sweet Melon Seeds Planted In Poly Bags |
Results on effects of Apron plus in Figure 11 above shows that there was a zero-seedling emergence in all the days due to phytotoxicity of the chemical on the seeds.
3.6. Isolation and Identification of fungi Organisms, associated with sweet melon seeds, using blotter paper method
The result showed that the fungi organisms isolated was identified as Aspergillus app and Penicillin spp. Based on the growth characteristics and fruiting bodies confirmed, using illustrated pictures of fungi by Barnett and Hunter (1999).
Plate 4
|
Plate 4 Pure Culture of Penicillium spp Isolated from Infected Sweet Melon Seeds (X 75%) |
Plate 5
|
Plate 5 Micrograph of Penicillium spp (Mg x 100) |
Plate 6

|
Plate 6 Pure Culture of Aspergillus Spp Isolated from Infected Sweet Melon Seeds (X 75%) |
Plate 7

|
Plate 7 Micrograph of Aspergillus spp (Mgx 100%) |
4. DISCUSSION
The results on germination of sweet melon seeds showed that there was significant effect of plant extract on germination percentage of sweet melon seeds using blotter paper method. This is in agreement with Coignaux (2013), who on his study on influence of Gongronema latifolium plant extract on sweet melon seeds revealed that there was moderate impact on germination of seeds of sweet melon. Seeds dressed in bio -medicinal plant crude powdery extracts of (Gongronema latifolium (Utazi) leaves and Myristica fragans (Nutmeg) seeds) germinated sparingly on sterilized soil. The seeds dusted with nutmeg gave the highest germination percentage. There was no significant effect of fungicide on germination percentage of sweet melon. This is in disagreement with Ibiam et al. (2008) who reported that use of seed dressers could control seed borne fungi of rice plant. The plant extracts being used as seed dressers could have had toxicity effect on the seeds and that would have been the possible reason why some of them did not germinate Ibiam et al. (2008). It was also observed that there was effective inhibition of fungal growth on sweet melon seeds dusted with crude powdery plant extracts of Gongronema latifolium (Utazi) leaves and Myristica fragans (Nutmeg) seeds) used in this investigation. This is in consonance with Iwuagwu et al. (2018b), who reported effective antifungal action of Pepper fruit (Dennettia tripetala H.) against Aspergillus niger isolated from infected Cocoyam leaves in Nigeria
The synthetic fungicide (Apron plus 60 SD) dusted seeds showed no emergence at all due to phytotoxicity of the chemical on the seed. This is in agreement with Munger (2013), who reported that there was low germination of seeds growth of sweet melon when synthetic fungicides were used.
The investigation also showed that it took up to seven days for germination in sweet melon seeds to be completed. This is in disagreement with Azad et al. (2011). who stated that on the average, it takes thirteen days for seeds sown to have complete germination. The synthetic fungicide (Alpron- plus) used in this investigation was more effective in controlling seed borne organisms than the crude powder of the medicinal plants used in this research. This is in agreement with Jangir et al. (2022) and Iwuagwu et al. (2018b), who reported that synthetic fungicides used in their investigations were very effective in the control of seed borne fungi of seeds.
The synthetic fungicide used in this experiment should not be used as dressers in powdery form as applied in this study because it was very phytotoxic to the seeds. This was shown by zero germination of the seeds in the polybag method. This is in agreement with Jangir et al. (2022).
, who stated that the use of synthetic fungicides as
dressers led to minimal or zero germination in seeds. Seed-borne organisms
isolated and identified in this research were Penicillium spp and Aspergillus spp which have been reported to responsible to loss of viability in most
stored seeds. This is in agreement to findings of Iwuagwu et al. (2018a) and Iwuagwu et al. (2019), who reported association of some fungi
pathogens with rice and Bambara groundnut seeds.
5. CONCLUSION
This study revealed that fungicides had significant effect on germination percentage and germination index of sweet melon seeds. Bio -medicinal plant crude extract of Gongronema latifolium had the highest germination index. The synthetic fungicide was more effective in protecting the seeds of sweet melon though had low germination percentage. Nutmeg was not effective when used in crude powdery form as dressers as it has the lowest germination percentage and the highest infestation percentage. The test synthetic fungicides due to its phytotoxic nature could not support the germination of the seeds though was effective in preventing the growth of fungi organisms.
RECOMMENDATIONS
It could therefore be recommended that the plant extracts that were tested in this experiment should not be used as powdery seed dressers but in an extracted form as essential oil using appropriate extracting solvents in order for the bioactive ingredients to act effectively in preventing micro-organisms that hinder germination of sweet melon seeds.
CONFLICT OF INTERESTS
None.
ACKNOWLEDGMENTS
None.
REFERENCES
Azad, S., Manik, R., Hasan, S., and Matin, A. (2011). Effect of Different Presowing Treatments of Seed Germination
Percentage and Growth Performance of Acacia Auriculiformis. Journal of Forestry
Research, 22(2), 183-188. https://doi.org/10.1007/s11676-011-0147-y.
Barnett, H.L. and Hunter, B.B. (1999). Illustrated Genera of Imperfect Fungi (4th Edition). The American Phytopathological Society St. Paul, Minoesota. 218.
Cobbley, H. C, Leslie, S. and Steele, W. M (1976). An Introduction to the Botany of Tropical Crops. 2nd ed., Longman Inc; New York, 371.
Coignaux, V.K. (2010). Studies on Genetic Variability and Correlation in Muskmelon (Cucumis Melo L.). In : International Seminar on Recent Trends In Hi-Tech Horticulture and Post-Harvest Technology, CSAUAT, Kanpur, February 4-6, 2004.
FAOSTAT (2017). "Production of Melons, Including Cantaloupes For 2016 (Crops/World Regions/Production Quantity From Pick Lists)". Food and Agriculture Organization of the United Nations.
ISTA (International Seed Testing Association) (2001). International Rules for Seed Testing. Rules Amendments. Seed Science Technology, 29, 1-127.
Ibiam, O.F.A., Umecuruba, C.I., and Arinze, A.E. (2008). A Survey of Seed-Borne Fungi Associated With Seeds of Rice (Oryzae Sativa L Faro12, 15, and 29) in Storage and the Field in Afikpo North Local Government Area of Ebonyi State. Scientia Africana, 7 (2), 1-4. https://doi.org/10.4314/sa.v7i2.46011.
Iwuagwu, C. C. Nwogbaga, A. C. Onejeme, F.C. Nduka, U. F. and Iheaturu, D. E. (2018b). In-Vitro Effect of Some Plant Extracts and Synthetic Fungicide in the Control of Cocoyam Leaf Necrotic Fungi in Aguata LGA, Anambra State. International Journal of Biotechnology and Food Science 6(5), 86-94.
Iwuagwu,
C.C., Kpadobi, R.C., Nwogbaga, A.C., Salaudeen. M.T., Iheaturu, D.E, and
Onejeme, F.C. (2019). Fungitoxic Effects of Some Plant Extracts on
Seedborne Fungi Pathogens of Bambara Groundnut in Awka South of Anambra State,
Nigeria. Advancement in Medicinal Plant Research 7(2), 44-53. https://doi.org/10.30918/AMPR.72.19.014.
Iwuagwu, C.C., Umechuruba, C.I., Ononuju, C.C., and Nwogbaga,
A.C. (2018a). Assessment of Seed-Borne Plant Pathogenic Fungi Associated
with Rice Crop in South-Eastern Nigeria. Journal of Agricultural Science and
Technology A 8, 68-75.
http://dx.doi.org/10.17265/2161-6256/2018.02.003.
Jangir, H, Ram, D and Choudhary, A. (2022). Management of Wilt Disease of Cumin Caused by F. Oxysporum F. Sp. Cumini With Fungicides In- Vitro and In -Vivo. The J. Res. PJTSAU 50(1), 101-107.
Limonard, T. A. (1966). Modified Blotter Test For Seed Health. Netherlands Journal of Plant Pathology 72, 319-321. https://doi.org/10.1007/BF02650226.
Milind, D.R. and Kulwant, K.H. (2011). A
Correlation and Path Coefficient Analysis of Components of Crested Wheat Grass
Seed. Agron. J., 51, 515-518. https://doi.org/10.2134/agronj1959.00021962005100090002x.
Munger, H.M. and Robinson, R.W. (1991). Nomenclature of Cucumis Melo L. Cucurbit Genetics Cooperative Report, 14, 43-44.
Nascimento Gislene, G.F., Locatelli, J., Freitas, P. C., and Silva, G. L. (2000). Braz. J. Microbiol. 31, 247 - 256. https://doi.org/10.1590/S1517-83822000000400003.
Niaz, I. and Dawar, S., (2009). Detection of Seed Borne Mycoflora in Maize (Zea Mays L.). Pak. J.Bot. 41(1), 443- 451.
Olayinka, B.U. and Etejere, E.O (2018). Proximate and Chemical Compositions of Watermelon(Citrullus Lanatus (Thunb.) Matsum and Nakai Cv Red and Cucumber (Cucumis Sativus L. Cv Pipino). International Food Research Journal 25(3), 1060-1066.
Petkova, Z. and Antova, G. (2015). Proximate Composition of
Seeds and Seed Oils from Melon (Cucumis Melo L.) Cultivated in Bulgaria. Cogent
Food Agric., 1(1), 1018779. https://doi.org/10.1080/23311932.2015.1018779.
Rajput, M.A., Pathan, M.A., Lodhi, A.M., Shah, G.S., and Khanzada, K.A. (2005). Studies on Seed-Borne Fungi of Wheat in Sindh Province and Their Effect on Seed Germination. Pak. J. Bot. 37(1), 181-185.
Rao, N.K., Hanson, J., Dulloo, M.E., Ghosh, K., Nowell, D. and Larinde, M. (2006). Manual of Seed Handling in Genebanks. Handbooks for Genebanks No. 8, Bioversity International, Rome, 28-3.
Rios, J.L. and Recio, M.C. (2005). Medicinal Plants and
Antimicrobial Activity. Journal of Ethnopharmacology, 100, 80-84. https://doi.org/10.1016/j.jep.2005.04.025.
Rubatzky, V. E. and Yamaguchi-Mas (1997). World
vegetables, Principles, Production and Nutritive value, 2nd ed., Chapman and
Hall, U.S.A, 577-639.
https://doi.org/10.1007/978-1-4615-6015-9_24.
Shafiei,
Z., Shuhairi N.N., Md Fazly Shah Yap, N., Harry Sibungki, C.A., and Latip, J.
(2012)."Antibacterial Activity of Myristica Fragrans Against Oral
Pathogens". Evidence-Based Complementary and Alternative Medicine, 1-7. https://doi.org/10.1155/2012/825362.
Srivastava, J., Lambert, J.,
and Vietmeyer, N. (1996). Medicinal Plants : An
Expanding Role in Development. World Bank Technical Paper. No. 320.1-36. https://doi.org/10.1596/0-8213-3613-4.
Van Du, P., Loan, L.C., Cuong, N.D., Nghiep, H.V., and Thach, N.D. (2001). Survey on Seed Borne Fungi and Its Effects on Grain Quality of Common Rice Cultivars In the Mekong Delta. Omonrice, 9, 107-113.
Walcott, R.R. (2003). Detection of Seedborne Pathogens.
Horttechnology 13, 40-47.
https://doi.org/10.21273/HORTTECH.13.1.0040.
This work is licensed under a: Creative Commons Attribution 4.0 International License
© Granthaalayah 2014-2022. All Rights Reserved.